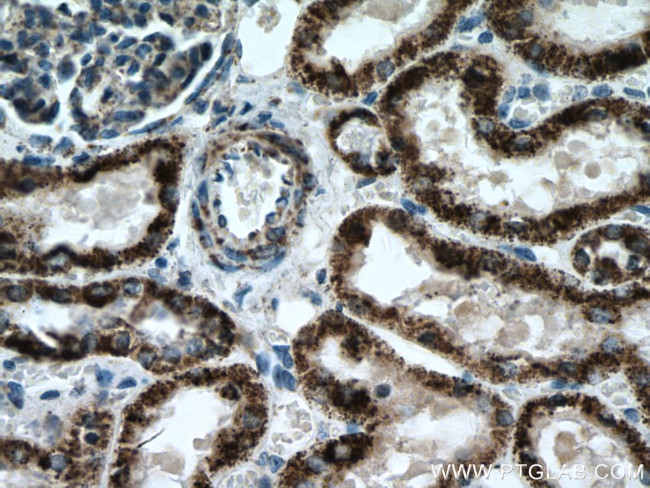
ALDH6A1 Antibody in Immunohistochemistry (Paraffin) (IHC (P))
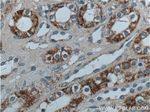
ALDH6A1 Antibody in Immunohistochemistry (Paraffin) (IHC (P))
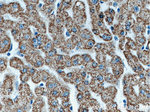
ALDH6A1 Antibody in Immunohistochemistry (Paraffin) (IHC (P))
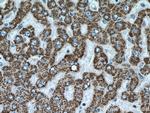
ALDH6A1 Antibody in Immunohistochemistry (Paraffin) (IHC (P))
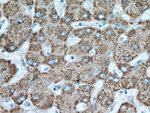
ALDH6A1 Antibody in Immunohistochemistry (Paraffin) (IHC (P))

Search
Proteintech
ALDH6A1 Polyclonal Antibody
{{$productOrderCtrl.translations['antibody.pdp.commerceCard.promotion.promotions']}}
{{$productOrderCtrl.translations['antibody.pdp.commerceCard.promotion.viewpromo']}}
{{$productOrderCtrl.translations['antibody.pdp.commerceCard.promotion.promocode']}}: {{promo.promoCode}} {{promo.promoTitle}} {{promo.promoDescription}}. {{$productOrderCtrl.translations['antibody.pdp.commerceCard.promotion.learnmore']}}
产品信息
20452-1-AP
种属反应
宿主/亚型
分类
类型
抗原
偶联物
形式
浓度
规格
纯化类型
保存液
内含物
保存条件
运输条件
产品详细信息
Immunogen sequence: WMFPMAMVC GNTFLMKPSE RVPGATMLLA KLLQDSGAPD GTLNIIHGQH EAVNFICDHP DIKAISFVGS NKAGEYIFER GSRHGKRVQA NMGAKNHGVV MPDANKENTL NQLVGAAFGA AGQRCMALST AVLVGEAKKW LPELVEHAKN LRVNAGDQPG ADLGPLITPQ AKERVCNLID SGTKEGASIL LDGRKIKVKG YENGNFVGPT IISNVKPNMT CYKEEIFGPV LVVLETETLD EAIQIVNNNP YGNGTAIFTT NGATARKYAH LVDVGQVGVN VPIPVPLPMF SFTGSRSSFR GDTNFYGKQG IQFYTQLKTI TSQWKEEDAT LSSPAVVMPT MGR (194-535 aa encoded by BC004909)
靶标信息
This protein belongs to the aldehyde dehydrogenases family of proteins. This enzyme plays a role in the valine and pyrimidine catabolic pathways. The product of this gene, a mitochondrial methylmalonate semialdehyde dehydrogenase, catalyzes the irreversible oxidative decarboxylation of malonate and methylmalonate semialdehydes to acetyl- and propionyl-CoA. Methylmalonate semialdehyde dehydrogenase deficiency is characterized by elevated beta-alanine, 3-hydroxypropionic acid, and both isomers of 3-amino and 3-hydroxyisobutyric acids in urine organic acids.
仅用于科研。不用于诊断过程。未经明确授权不得转售。
生物信息学
蛋白别名: Aldehyde dehydrogenase family 6 member A1; aldehyde dehydrogenase family 6, subfamily A1; malonate-semialdehyde dehydrogenase; malonate-semialdehyde dehydrogenase (acetylating); Malonate-semialdehyde dehydrogenase [acylating]; methylmalonate semialdehyde dehydrogenase; methylmalonate-semialdehyde dehydrogenase [acylating], mitochondrial; Methylmalonate-semialdehyde/malonate-semialdehyde dehydrogenase [acylating], mitochondrial; MGC40271; mitochondrial acylating methylmalonate-semialdehyde dehydrogenase; MMSDH; testicular tissue protein Li 122; unnamed protein product
基因别名: 1110038I05Rik; AI314632; ALDH6A1; MMSADHA; MMSDH
UniProt ID: (Human) Q02252, (Rat) Q02253, (Mouse) Q9EQ20
Entrez Gene ID: (Human) 4329, (Rat) 81708, (Mouse) 104776